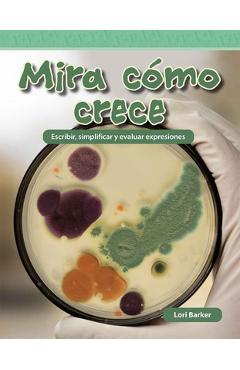
Coperta cărții 'Mira Cómo Crece: Escribir, Simplificar Y Evaluar Expresiones - Lori Barker'

7-10 Ani
Pentru a susține această evoluție, este important să se ofere acces la o gamă diversificată de povești, de la cele clasice, care cultivă valorile morale și imaginația, până la cărțile educative, ce îmbogățesc cunoștințele despre lume. Cărțile de activități și cele care promovează dezvoltarea personală joacă, de asemenea, un rol important în formarea unui caracter echilibrat și în dezvoltarea abilităților sociale.
Alegerea cărților potrivite pentru această vârstă trebuie să țină cont de nivelul de înțelegere al copilului, de interesele sale și de gradul de dificultate al textului. Este recomandat să se înceapă cu lecturi accesibile, care să stârnească plăcerea de a citi, iar treptat, să se introducă texte mai complexe, ce stimulează gândirea critică și capacitatea de analiză.
Lectura are un rol crucial în dezvoltarea cognitivă și emoțională a copiilor. Prin intermediul cărților, aceștia își îmbogățesc vocabularul, își dezvoltă imaginația, învață să empatizeze cu personajele și să înțeleagă diferite perspective asupra lumii. Lectura contribuie, de asemenea, la dezvoltarea abilităților de concentrare, memorare și comunicare.
Cum pot să știu dacă o carte este potrivită pentru copilul meu?
Este important să ții cont de nivelul de lectură al copilului, de interesele sale și să verifici recomandările de vârstă ale editurii.
Ce tipuri de cărți sunt cele mai potrivite pentru copiii de această vârstă?
Cele mai potrivite sunt cărțile de aventuri, poveștile educative, romanele pentru copii și biografiile adaptate.
Cât de mult ar trebui să citească un copil de această vârstă?
Este recomandat ca un copil de această vârstă să citească cel puțin 30 de minute pe zi, dar cel mai important este să citească cu plăcere.